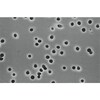
�|���J�[�{�l�[�g�^�C�v�����u�����t�B���^

4商品
| 商品ラインアップ |
メーカー品番
|
数量
|
販売価格
|
カート |
|---|---|---|---|---|
|
|
16020002
|
1梱(100枚入)
|
¥26,862
(税込)
|
¥26,862 (税込) |
|
|
16020004
|
1梱(100枚入)
|
¥35,530
(税込)
|
¥35,530 (税込) |
|
|
16040002
|
1梱(100枚入)
|
¥26,862
(税込)
|
¥26,862 (税込) |
|
|
16040004
|
1梱(100枚入)
|
¥35,530
(税込)
|
¥35,530 (税込) |
共通の商品仕様 (各商品の仕様は、商品詳細ページでご確認ください)
各商品の仕様は、商品詳細ページでご確認ください
|
| 注意事項 |
※【返品に関するご注意】この商品は直送品のため、お客様のご都合による返品はお受けできません。 ※【お届けに関するご注意】画面に表示されているお届け予定日までにお届け致します。 ※実際のお届けが予定日より早まる場合がございます。 ※また本商品には、出荷元発行の『納品書』もしくは『出荷ご案内書』が同梱されております。 ※カウネット発行の納品書は、商品到着後ご注文履歴より印刷可能です。 ※本商品はお届け先の状況次第では、車上渡しとなります。 ※荷降ろしの際は予め人員の確保やフォークリフト・台車等のご準備をお願い致します。 |
|---|